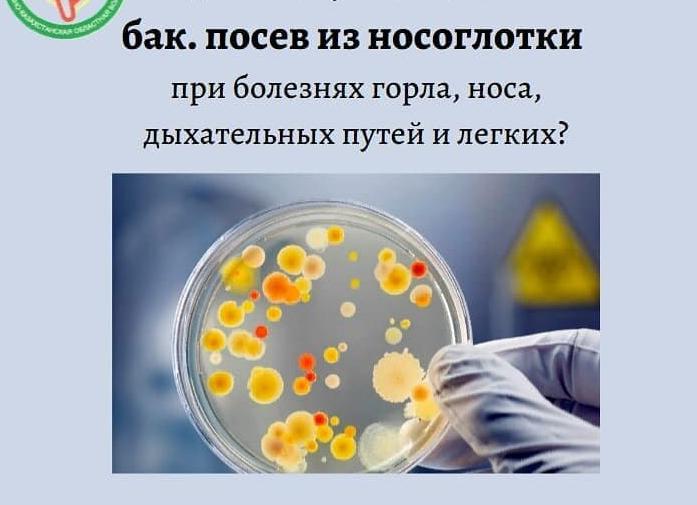
Бак посев из зева
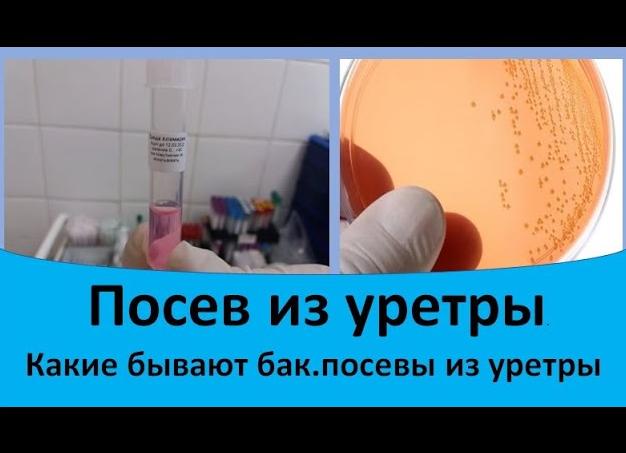
Бак посев из уретры у мужчин что показывает

Бак посев на дизентерийную группу
[Бак посев на дизентерийную группу]
Анализ на дизентерию: как сдавать, сроки и методы диагностики
Острые заболевания лечатся незамедлительно. Анализ на дизентерию должен удовлетворять критерию скорости. У взрослых и детей фиксируется и хроническая форма. Тогда проводится анализ кала на дизентерию. Можно это сделать в рамках анализа состава микрофлоры, как при дисбактериозе. Принцип выращивания аналогичный. Быстрый результат даёт наблюдение в микроскоп.